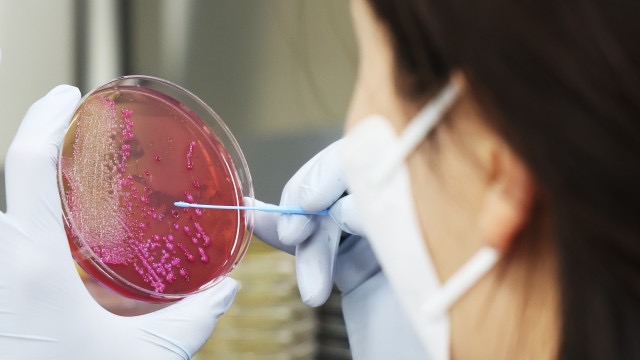

전북 남원지역 24개 학교에서 발생한 식중독 의심 환자가 1000명을 넘어섰습니다. 이들 학교가 공통으로 납품받은 김치에서 노로바이러스가 검출된 것으로 알려졌습니다.
노로바이러스: 급성 위장관 감염의 주요 원인
노로바이러스는 급성 위장관 감염을 일으키는 바이러스 중 하나로, 오염된 식음료나 환자와의 접촉 등을 통해 감염됩니다. 노로바이러스는 특히 저온에서도 잘 견디며, 사람 간 전염력이 강해 겨울철에 많이 발생하는 경향이 있습니다. 그러나 여름철에도 대거 발생한 사례가 있습니다. 질병관리청의 노로바이러스 환자 발생 추이(2020∼2024)를 보면, 2022년 여름철(29∼31주차)에도 발병이 두드러졌습니다.
노로바이러스 증상과 치료
노로바이러스의 주요 증상으로는 구토와 설사가 있으며, 소아는 주로 구토가, 성인은 주로 설사가 나타납니다. 설사는 물 같은 양상을 띠며, 대부분 48~72시간 동안 지속되다가 빠르게 호전되는 양상을 보입니다. 그 외에도 근육통, 두통, 발열 등의 전신 증상이 동반될 수 있으며, 보통 24~48시간 정도의 잠복기를 가집니다.
항바이러스 백신이 따로 없으며, 특별한 치료 없이 며칠 내로 자연적으로 회복됩니다. 다만, 탈수가 발생할 수 있어 스포츠 음료나 이온 음료로 수분을 공급해 주는 것이 좋습니다. 설탕 함유량이 높은 탄산음료나 과일 주스는 피해야 합니다. 심한 탈수나 전해질 불균형이 발생한 일부 환자는 입원 치료나 정맥 주사를 통한 수액 요법 치료가 필요할 수 있습니다.
노로바이러스 예방 및 관리
노로바이러스는 한 번 걸렸더라도 면역 유지 기간이 짧고 변이가 많아 재감염될 수 있습니다. 예방을 위해서는 손 씻기 등 개인위생 수칙을 잘 지키고, 음식을 흐르는 물에 씻어 충분히 익혀 먹으며, 물은 끓여 마셔야 합니다. 칼이나 도마는 소독하는 것이 중요합니다. 화장실 사용 후, 기저귀 교환 후, 식사 전이나 음식 준비 전에는 반드시 비누와 흐르는 물을 사용해 손을 깨끗이 씻어야 합니다.
순천향대 부천병원 감염내과 박성희 교수는 “노로바이러스 감염증 환자가 발생하면 주변 사람에게 전파되지 않도록 생활 공간을 분리하고, 오염된 주변 환경을 소독제로 세척하고 살균해야 한다”며 “환자는 배변 후 물을 내릴 때 변기 뚜껑을 닫아 비말 확산을 최소화하고, 구토물은 적절히 폐기 후 잘 소독해야 합니다. 증상이 호전되고 48시간 이상 등원, 등교 및 출근을 제한해야 합니다”라고 조언했습니다.
'정보제공' 카테고리의 다른 글
| 프랑스 총선 좌파연합勝 (0) | 2024.07.08 |
|---|---|
| 세종시 아파트 시세 반토막 (0) | 2024.07.08 |
| 김건희 한동훈의 읽씹 논란: 나경원과 원희룡의 비판 (0) | 2024.07.06 |
| 9급 1호봉 급여 얼마야? (0) | 2024.07.06 |
| 남원시 집단 식중독 원인 (0) | 2024.07.05 |